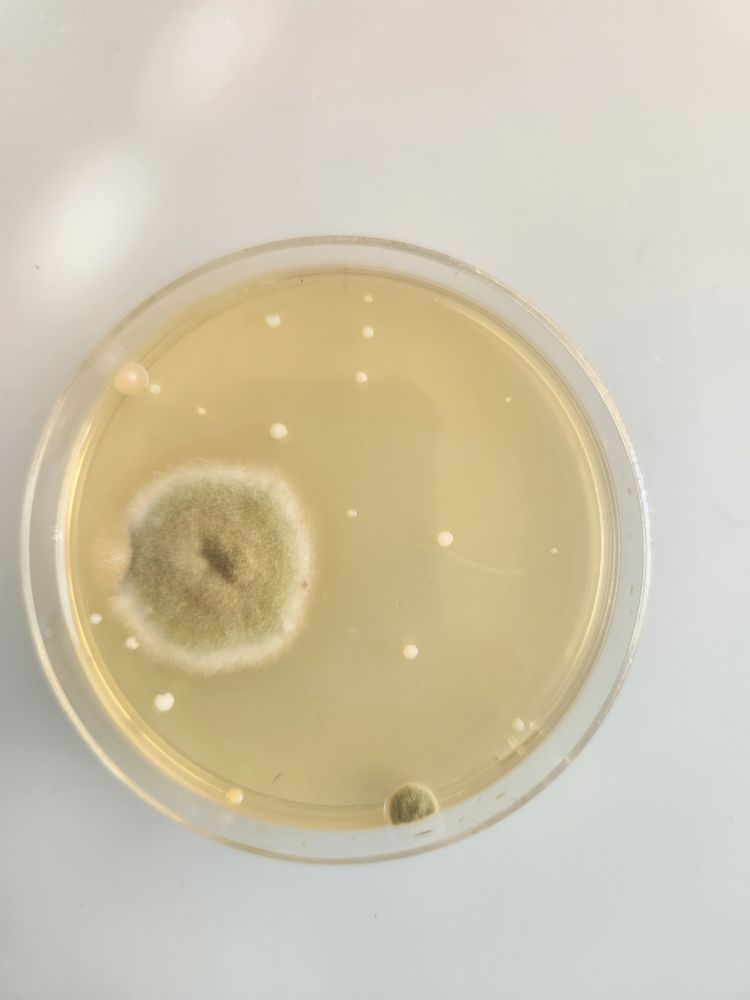
Huff Management Co - property management company in Opelika, AL

Huff Management Co
Property Management Company in Opelika, Alabama
Client Reviews
About Huff Management Co
Huff Management Co at 6060 Lee Road 54 is a Opelika-based provider of apartments. They have a 1.0-star Yelp rating from 3 reviews. They are listed under apartments.
How They Can Help
Huff Management Co handles apartments in Opelika. If you are looking for housing, especially with a voucher or other assistance, call (334) 749-0885 to ask what units are available and what programs they accept.
What to Expect
Start by calling (334) 749-0885 to ask about availability and application requirements. Have your ID, proof of income, rental history, and voucher paperwork ready.
Service Area
Huff Management Co is at 6060 Lee Road 54 in Opelika, AL. They serve the local area and surrounding communities.
Frequently Asked Questions
How much is rent at Huff Management Co properties?
Does Huff Management Co accept housing vouchers?
Where is Huff Management Co?
What if my voucher is about to expire?
How long does the application process take?
Preparing for an NSPIRE Inspection?
VoucherReady helps landlords and tenants prepare for NSPIRE inspections with property-specific checklists and compliance documentation.
Start Inspection Prep